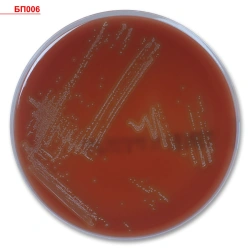

Russian Chemicals & Cleaners Products

Import Chemical substances and chemical products Globally
Connect with Russian manufacturers for reliable and affordable equipment
Featured Products


VD-AC paint for ceilings BTB

Juicy Cream Solid Toilet Soap "Sea Minerals+Detox Cream"

Biocidal complex SKUNS -01

Magnesium oxide for vacuum deposition

BiMax Color Washing Gel Orleans Jasmine

Additive to concrete "Kratasol-E" powder

Concentrate for removal of lime scale and rust "Kochizot"

Weakly toxic antiseptic-antipyrene for wood BB-11

Maunfeld Purity Conditioner-Rinse Aid Dawn Symphony

Liquid dishwashing detergent "Biolan Lime"

Start moisture resistant paint

Krestovnikov Brothers' Factory Almond" solid toilet cream soap
Nutrient dense multipurpose medium, ready to use, Trypticase-soya agar with addition of defibrinated K

Shampoo ZBK Kupazh #2

Titanium (II) oxide for vacuum deposition

VD Rubber Paint VTV

Sorti Aroma Magnolia liquid capsule laundry detergent

Liquid soap "Traditional. Children's"

Wood treatment agent Dezoprof BUILDER

Emulsion KE-10-34

Additive "AUX"

SORTI Dishwashing Dishwashing Agent Glycerine and Mint Hand Gentleness

Water dechlorination agent "DECHLOR"

Dishwashing Gel I WAS BORN FOR CHILDREN'S POOLS

Biopyrene (flame retardant-antiseptic) for wood Pirilax Classic bucket 11kg

Concrete admixture "Kratasol MFS" 30% solution

VK-51 adhesive film

DEZOKSIL OF-S Concentrate for degreasing and amorphous phosphating of metals

VD acrylic lacquer glossy VTV

Fire-bio-protective composition for wood I/ II gr PROFIWOOD colourless

Air freshener "Sunny Day" "Anti-tobacco Juicy citrus" in aerosol package

Universal powdered laundry detergent "Krestovnikov Brothers' Factory. Traditions of quality. Childhood. Color"

Detergent synthetic powdery universal "AOS Color Automat"

Ammonium tungstate

PF-115 "Start" enamel

Biolan Powder deodorising agent For country toilets

Reagent kit for the detection and quantification of Epstein-Barr virus (EBV) DNA by polymerase chain reaction with

BiMax Osmanthus liquid capsule laundry detergent

Fire-bio-protective agent for wood "SLAVIA OGNESCHIT-I"

Solid toilet soap "Healing herbs Calendula"

221040 BRAUBERG antibacterial finger moisturising gel, 25 g

BiMax BiMax Cokel Laundry Conditioner-Rinse Aid Osmanthus Flowers

De-icing material Talvi Storm Plus

BIOLAN Orange and Lemon Dishwashing Agent

Antiseptic Nortex-Lux for concrete bucket 0.9kg

BIOLAN Dishwashing Dishwashing Agent Sea Buckthorn Balm

Niobium (V) oxide for thin layer optics

SORTI Rosemary and Eucalyptus dishwashing detergent

Membrane for TMT-UFPS-A module
About Chemicals & Cleaners
Welcome to our Chemicals & Cleaners category, your comprehensive source for essential business supplies in Africa, the Middle East, and South Asia. Whether you're an importer, distributor, or a retail business, our products help you tackle diverse operational needs efficiently.
Our largest subcategory, Soap, Cleaners & Cosmetics, offers solutions for maintaining hygiene and cleanliness in spaces such as restaurants, hospitals, and schools. From industrial-grade detergents to gentle personal care items, these products cater to various demands, ensuring cleanliness and safety.
The Chemical Specialty Products section addresses niche requirements in industries like manufacturing, pharmaceuticals, and agriculture. These products, including solvents and adhesives, are critical for production processes that require precision and reliability.
Chemical Raw Materials serve as the building blocks for numerous industries. Essential for manufacturing, these materials support production in areas such as plastics, textiles, and construction. Access to quality raw materials can enhance your production capabilities and expand your product offerings.
Paints and Coatings provide protective and aesthetic solutions for buildings, vehicles, and machinery. Construction firms and automotive workshops benefit from these products, which are designed to withstand local climate conditions and ensure durability.
Our Pesticides & Agrochemicals are vital for the agricultural sector, helping farmers increase crop yields and manage pests effectively. These products are crucial for ensuring food security and supporting agribusiness growth in the region.
Chemical Fibres are used in the production of textiles and garments, offering opportunities for businesses in the fashion and home furnishings industries to enhance their product lines with durable and versatile materials.
In the African market, access to high-quality chemicals and cleaners is essential for maintaining competitiveness and meeting consumer demand. By sourcing these products, you can improve operational efficiency, enhance product quality, and ultimately, increase profitability. Did you know that the global chemical industry is a multi-billion dollar sector, with significant contributions from emerging markets? This highlights the potential for growth and the importance of being part of this dynamic industry.
Explore our Chemicals & Cleaners category to find the right products to buy, import, and integrate into your business operations. With competitive prices and a wide range of options, we are here to support your success in these thriving markets.
How to Order Chemicals & Cleaners Products from Russia
What You'll Need:
- Product specifications
- Import documentation
- Payment method
- Delivery address
- Contact information
Step-by-Step Instructions:
-
Product Selection
Select the products you're interested in from the catalog or send us a request with technical requirements -
Commercial Proposal
Receive a commercial proposal directly from suppliers -
Agreement on Terms
Agree on shipping conditions, prices, and terms -
Contract and Payment
Conclude the contract and make the payment -
Delivery Tracking
Track the delivery status through our platform
Result: Successfully imported Chemicals & Cleaners products from Russia
Benefits of Ordering Products through Tonzar
- Direct Contact with Manufacturers — without intermediaries and markups
- Verified Suppliers — we work only with reliable companies
- Complete Deal Management — from request to delivery
- Quality Guarantee — all products meet Russian and international standards
- Worldwide Delivery — full logistics support
Frequently Asked Questions
To order products from Russia through our platform, select the product you're interested in, click the "Request Quote" button, and fill out the request form. Our managers will contact you to clarify the details and provide a commercial proposal.
We offer various payment methods, including prepayment, partial payment, irrevocable letter of credit, and other options. Payment terms are discussed individually for each deal and depend on the order volume, delivery country, and supplier requirements.
We deliver Russian products to any point in the world. Our company has well-developed logistics routes and partnership relationships with transport companies, which allows us to organize delivery as efficiently as possible.
Yes, we work with requests for supply of products that are not in our catalog. Send us a technical assignment or describe the required product, and we'll find a suitable manufacturer in Russia.